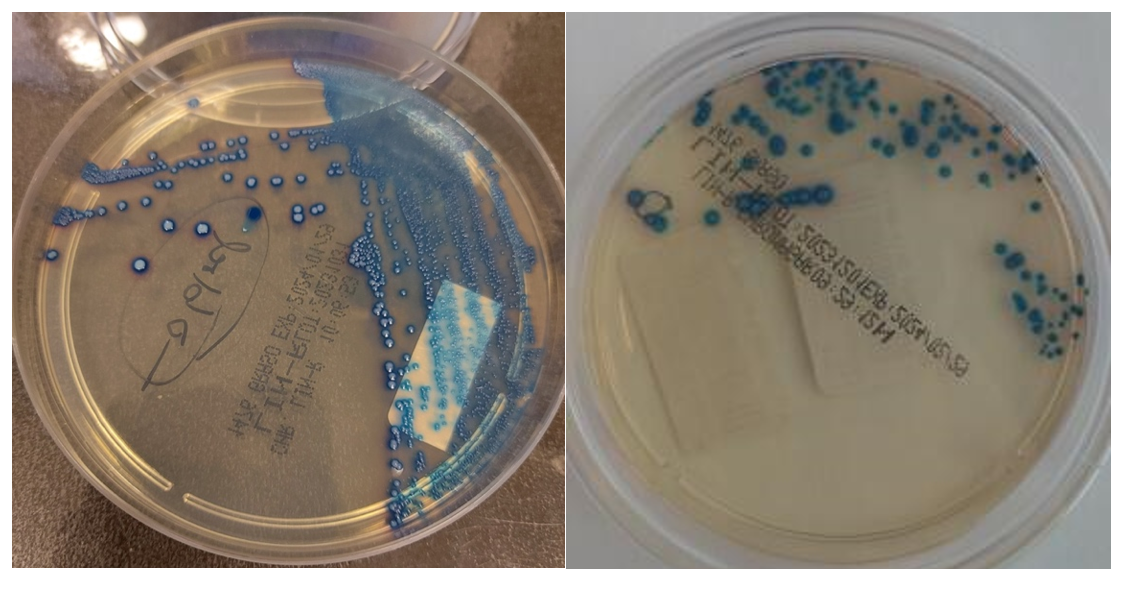
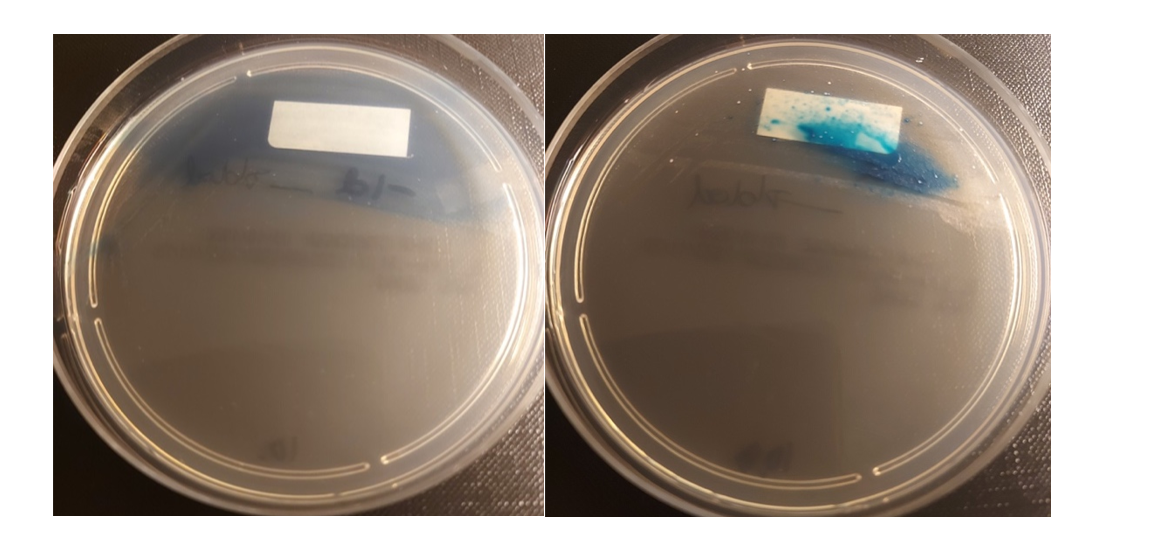

Screening for linezolidresistente enterokokker – erfaringer fra pågående multisenterstudie
K-res vil med dette oppsummere egne erfaringer fra pågående europeisk multisenter hvor selektivt kommersielt medium har vært evaluert for screening etter linezolidresistente enterokokker.
Flere laboratorier ønsker å starte LRE-screening etter sporadiske funn og har i den forbindelse etterspurt råd om bruk av LRE-screeningsagar.
Linezolidresistente enterokokker – forekomst og mekanismer for resistens
Epidemiologi
Linezolid anses for å være siste skanse i behandlingen av infeksjoner med multiresistente enterokokker, inkludert vankomycinresistente enterokokker. Forekomsten av linezolidresistens blant kliniske enterokokker (LRE) er fortsatt lav (<1%) på verdensbasis (1), men økende i mange land (2,3). I NORM rapporten for 2023 ble 0,5% av invasive Enterococcus spp (n=753) og 1,9% av Enterococcus faecium (n=209) kategorisert som R, mens alle invasive Enterococcus faecalis (n=515) fortsatt ble kategorisert som S (4). K-res som nasjonalt referanselaboratorium for LRE, har siden det første tilfellet av LRE ble påvist i Norge i 2012 registrert fra ett til 66 tilfeller i året, med en økende trend siste årene (5). Slektskapsanalyser og epidemiologiske data har de siste årene vist tilfeller av innenlands smittespredning, og i 2021 ble det første sykehusutbrudd med LRE registrert i Norge (6).
Mekanismer
Linezolid binder seg til ribosomet og hemmer bakteriens proteinsyntese. Typiske resistensmekanismer hos enterokokker er kromosomale mutasjonsbaserte endringer i ribosomalt RNA og ervervede gener (optrA og poxtA) som produserer proteiner som beskytter ribosomet mot binding av linezolid. Både optrA og poxtA er lokalisert på mobile genetiske elementer og gir kryssresistens mot flere typer antibiotika (fenikolgruppen) som binder til ribosomet (2,7,8). Mutasjonsbasert resistens opptrer oftest i forbindelse med behandling med oxazolidinoner (9). Den mest vanlige kromosomale mutasjonen som forårsaker linezolidresistens er G2576U mutasjon i 23S rRNA V domenet. De fleste bakteriearter har mer enn en kopi av 23S rRNA genet i genomet og resistensnivået korrelerer med antall kopier som har mutasjonen (10,11).
Screening
På grunn av den lave forekomsten av linezolidresistens generelt i Gram-positive bakterier (1) har det først de siste årene vært fokus på å utvikle selektive dyrkingsmedia for screening av linezolidresistente Gram-positive bakterier. Vi gjorde i 2022 en litteraturgjennomgang og oppsummerte resultater fra validerte vekstmedier for screening etter linezolidresistente Gram-positive bakterier inkludert LRE (Screening for LRE). Det er ikke publisert nye valideringer siden den gang, og det er fortsatt kun et kommersielt (Chromagar™ Lin-R) medium tilgjengelig som har vært validert i to uavhengige publikasjoner (12,13). Referanselaboratoriet for påvisning av LRE i Tyskland har ledet en nasjonal multisenterstudie hvor denne skåla ble testet ut i rutine screening av linezolidresistens (14) og leder nå en europeisk multisenterstudie hvor K-res og OUS Rikshospitalet har vært med og testet ut ferdiglagede Chromagar™ Lin-R plater fra leverandøren.
Chromagar™ Lin-R er et kromogent medium som er designet for deteksjon og differensiering av Gram-positive bakterier som er resistente mot linezolid direkte fra prøvematerialet. Det er ikke beregnet for verifisering av linezolidresistens i enkeltisolater. Mediet kan fås som pulver eller ferdige plater. LRE opptrer typisk som stålblå kolonier med blå halo/skygge rundt på Chromagar™ Lin-R platen etter 36-48 timers inkubering (Figur 1). Skåla kan også brukes for å detektere linezolidresistente stafylokokker direkte fra prøvematerialet. Stafylokokker vil opptre som rosa kolonier med rosa halo (CHROMagar™ LIN-R). Deteksjon av linezolidresistente stafylokokker var ikke formålet for uttesting på K-res og OUS Rikshospitalet.
Foto: Mehrzad Akbari
Figur 1. Vekst av tydelige blå kolonier fra LRE positiv renkultur (venstre) og LRE fra feces etter anrikning i Enterococcosel med aztreonam (høyre).
Erfaring med bruk av Chromagar™ Lin-R og anbefalinger
Man kan også få falsk positiv blå slørvekst ved direkteutsæd fra fekalt prøvemateriale som vist i Figur 2. I begynnelsen lette vi etter LRE i slørveksten fordi den var blå, men gjentatte spredninger fra slørveksten kunne ikke verifiseres som LRE. Blå slørvekst bør derfor ignoreres. Erfaring fra OUS Rikshospitalet viser videre at anrikning av enterokokker i Enterococcosel buljong med 60 mg/L aztreonam før utsæd på Chromagar™ Lin-R platen kan gjøre det lettere å lese av skåla.
Skålene bør inkuberes i 36-48 timer som anbefalt fra leverandør. Vi observerte at for enkelte LRE varianter var det svak vekst på dag 1, mens reelle blå kolonier først ble observert på dag 2. For andre LRE varianter med høyere linezolid MIC var det god vekst allerede på dag 1. Siden vi i Norge har mange LRE med MIC rundt brytningspunktet, er det spesielt viktig å inkubere minst 36 timer for å sikre at man detekterer også slike LRE varianter.
For verifisering av LRE anbefaler vi disk diffusjon før genetisk påvisning. Tidligere evaluering av fenotypisk påvisning av linezolidresistens hos enterokokker på K-res i samarbeid med EUCAST Development Laboratory har vist at det kan være utfordrende å påvise LRE da noen av stammene med kjente resistensmekanismer kan ha grenseverdier for følsomhet (sone på 20 mm og MIC-verdier på 4 mg/L) (15), men våre resultater fra NordicAST multisenter studie viser at EUCAST diskdiffusjonsmetode er pålitelig for klinisk kategorisering av linezolidfølsomhet hos E. faecalis and E. faecium. I NordicAST studien observerte vi også en trend i evnen til diskdiffusjonsmetoden i å forutsi resistens i stammer med en definert resistensmekanisme, men en MIC på 4 mg/L som er S brytningspunkt (16).
Det er viktig med god kontroll av skålene og å bruke kontrollstammer som anbefalt av produsenten. K-res kan også distribuere andre kontrollstammer til laboratoriene om ønskelig. K-res har blant annet kontrollstamme med lavgradig linezolid MIC som vi brukte for å verifisere skålene. Husk at et tykt inokulat av følsomme enterokokkstammer kan gi falsk positiv slørvekst, men ikke blå enkeltkolonier.
For spørsmål kontakt Kristin Hegstad (Kristin.Hegstad@uit.no) eller Siv-Heidi Barkhald (Siv-Heidi.Barkhald@unn.no) ved K-res eller Jørgen V. Bjørnholt (joerbj@ous-hf.no) ved OUS Rikshospitalet.
Referanser
- Mendes RE, Hogan PA, Jones RN, Sader HS, Flamm RK. 2016. Surveillance for linezolid resistance via the ZYvox(R) Annual Appraisal of Potency and Spectrum (ZAAPS) programme (2014): evolving resistance mechanisms with stable susceptibility rates. J Antimicrob Chemother 71:1860-5. doi: 10.1093/jac/dkw052.
- Bender JK, Cattoir V, Hegstad K, Sadowy E, Coque TM, Westh H, Hammerum AM, Schaffer K, Burns K, Murchan S, Novais C, Freitas AR, Peixe L, Del Grosso M, Pantosti A, Werner G. 2018. Update on prevalence and mechanisms of resistance to linezolid, tigecycline and daptomycin in enterococci in Europe: towards a common nomenclature. Drug Resist Updat 40:25-39. doi: 10.1016/j.drup.2018.10.002.
- Klare I, Fleige C, Geringer U, Thürmer A, Bender J, Mutters NT, Mischnik A, Werner G. 2015. Increased frequency of linezolid resistance among clinical Enterococcus faecium isolates from German hospital patients. J Glob Antimicrob Resist 3:128-31. doi: 10.1016/j.jgar.2015.02.007.
- NORM/NORM-VET 2023. Usage of Antimicrobial Agents and Occurrence of Antimicrobial Resistance in Norway. Tromsø / Oslo 2024. ISSN:1502-2307 (print) / 1890-9965 (electronic).
- Vancomycin resistant enterococci and linezolid resistant enterococci in Norway 2023, by Hegstad K, Saare M, Sundsfjord A, p. 153-158 in NORM/NORM-VET 2023. Usage of Antimicrobial Agents and Occurrence of Antimicrobial Resistance in Norway. Tromsø/Oslo 2024. ISSN:1502-2307 (print)/1890-9965 (electronic).
- Vancomycin and linezolid resistant enterococci in Norway 2021, by Hegstad K, Janice J, Sundsfjord A, Elstrøm P, Kacelnik O, p. 127-132 in NORM/NORM-VET 2021. Usage of Antimicrobial Agents and Occurrence of Antimicrobial Resistance in Norway. Tromsø/Oslo 2022. ISSN:1502-2307 (print)/1890-9965 (electronic).
- Sadowy E. 2018. Linezolid resistance genes and genetic elements enhancing their dissemination in enterococci and streptococci. Plasmid 99:89-98. doi: 10.1016/j.plasmid.2018.09.011.
- Crowe-McAuliffe C, Murina V, Turnbull KJ, Huch S, Kasari M, Takada H, Nersisyan L, Sundsfjord A, Hegstad K, Atkinson GC, Pelechano V, Wilson DN, Hauryliuk V. Structural basis for PoxtA-mediated resistance to phenicol and oxazolidinone antibiotics. Nature Comm 13:1860. doi: 10.1038/s41467-022-29274-9.
- McGregor JC, Hartung DM, Allen GP, Taplitz RA, Traver R, Tong T, Bearden DT. 2012. Risk factors associated with linezolid-nonsusceptible enterococcal infections. Am J Infect Control. 40:886-7. doi: 10.1016/j.ajic.2011.11.005.
- Beukers AG, Hasman H, HegstadK, van Hal SJ. 2018. Recommendations to address the difficulties encountered when determining linezolid resistance from whole genome sequencing data. Antimicrob Agents Chemother. pii: AAC.00613-18. doi: 10.1128/AAC.00613-18.
- Marshall SH, Donskey CJ, Hutton-Thomas R, Salata RA, Rice LB. 2002. Gene dosage and linezolid resistance in Enterococcus faecium and Enterococcus faecalis. Antimicrob Agents Chemother 46:3334-6. doi: 10.1128/AAC.46.10.3334-3336.2002.
- Dembicka KM, Powell J, O'Connell NH, Hennessy N, Brennan G, Dunne CP. 2021. Prevalence of linezolid-resistant organisms among patients admitted to a tertiary hospital for critical care or dialysis. Ir J Med Sci. doi: 1007/s11845-021-02773-2
- Layer F, Weber RE, Fleige C, Strommenger B, Cuny C, Werner G. 2021. Excellent performance of CHROMagarTMLIN-R to selectively screen for linezolid-resistant enterococci and staphylococci. Diagn Microbiol Infect Dis 99:115301. doi: 10.1016/j.diagmicrobio.2020.115301
- Bender JK, Baufeld E, Becker K, Claus H, Dudakova A, et al. 2023. CHROMAgar™ LIN-R as an efficient screening tool to assess the prevalence of linezolid-resistant enterococci in German hospital patients - a multicentre study approach, 2021-2022. J Antimicrob Chemother 202378:2185-2191. doi: 10.1093/jac/dkad218.
- Haldorsen B, Matuschek E, Åhman J, Kahlmeter G, Sundsfjord A, Hegstad K. 2021. Performance of the EUCAST disc diffusion method and gradient tests in detection of linezolid susceptibility in Enterococcus faecalis and Enterococcus faecium. 31th European Congress of Clinical Microbiology and Infectious Diseases, Online/Viennea, Austria.
- Haldorsen BC, Småbrekke L, Matuschek E, Skjold F, Augustinussen M, Helgason KO, Holzknecht B, Ilmavirta H, Kahlmeter G, Sundsfjord A, Hegstad K, the NordicAST LRE-TRE study group. Performance of the EUCAST disk diffusion method for linezolid susceptibility testing in enterococci: a Nordic multicentre study. Poster P1580 34th European Congress of Clinical Microbiology and Infectious Diseases, Barcelona, Spain.